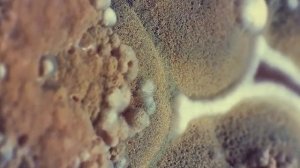
ОТКУДА БЕРЁТСЯ ПЛЕСЕНЬ?ИНТЕРЕСНЫЕ ФАКТЫ.

4:16
4:16
2023-11-13 20:01
![Плесень.]() 1:39:10
1:39:10
 1:39:10
1:39:10
2009-02-14 01:01
![Плесень]() 1:19:38
1:19:38
 1:19:38
1:19:38
2009-06-18 08:13

 1:55:05
1:55:05

 1:55:05
1:55:05
2026-04-26 21:00

 10:54:47
10:54:47

 10:54:47
10:54:47
2026-04-30 00:03

 3:00:35
3:00:35

 3:00:35
3:00:35
2026-04-30 11:52

 11:40:36
11:40:36

 11:40:36
11:40:36
2026-04-30 00:01

 2:36:33
2:36:33

 2:36:33
2:36:33
2026-04-24 17:06

 1:49:24
1:49:24

 1:49:24
1:49:24
2024-10-26 19:12

 3:12:39
3:12:39

 3:12:39
3:12:39
2026-04-02 00:05

 3:00:33
3:00:33

 3:00:33
3:00:33
2025-04-06 21:40

 2:50:57
2:50:57

 2:50:57
2:50:57
2025-05-03 17:08

 3:48:10
3:48:10

 3:48:10
3:48:10
2023-09-18 01:16

 2:57:10
2:57:10

 2:57:10
2:57:10
2023-09-17 17:03

 2:16:05
2:16:05

 2:16:05
2:16:05
2025-01-18 21:00

 11:26:05
11:26:05

 11:26:05
11:26:05
2026-04-30 00:01

 2:40:57
2:40:57

 2:40:57
2:40:57
2025-12-17 16:07

 2:23:16
2:23:16
![Enrasta - Адьёс (Премьера клипа 2026)]() 3:45
3:45
![Соня Белькевич, КРЕСТОВ - Станцуем (Премьера клипа 2026)]() 3:25
3:25
![Sabi, MIA BOYKA - Базовый минимум (Премьера клипа 2026)]() 2:26
2:26
![Cvetocek7 - Неспокойно без тебя (Премьера клипа 2026)]() 2:34
2:34
![NITI DILA - Белые лебеди (Премьера клипа 2026)]() 2:30
2:30
![StaFFорд63 - Наступит день (Премьера клипа 2026)]() 3:04
3:04
![Альберт Эркенов - По привычке (Премьера клипа 2026)]() 2:54
2:54
![Дана Лахова - Сердечко (Премьера клипа 2026)]() 3:15
3:15
![Игорь Кибирев - Уйду в туман (Премьера клипа 2026)]() 3:50
3:50
![Артур Пирожков - Самый красивый (Премьера клипа 2026)]() 2:16
2:16
![Сергей Завьялов - А ты не мучай (Премьера клипа 2026)]() 2:45
2:45
![Ислам Мальсуйгенов, Зульфия Чотчаева - Заиграла любовь (Премьера клипа 2026)]() 2:15
2:15
![Кямал Узденов - До боли до безумия (Премьера клипа 2026)]() 2:41
2:41
![Винтаж - Малахит (Премьера клипа 2026)]() 3:44
3:44
![ЕГОР КРИД & ARTIK & ASTI - KARMA (Премьера клипа 2026)]() 2:59
2:59
![Фати Царикаева - Ну и что (Премьера клипа 2026)]() 2:41
2:41
![Альберт Эркенов - Непокорная (Премьера клипа 2026)]() 4:04
4:04
![Tural Everest - Блестящая (Премьера клипа 2026)]() 2:44
2:44
![Ислам Итляшев - Вижу ее (Премьера клипа 2026)]() 2:50
2:50
![AzaLi - Стерва (Премьера клипа 2026)]() 2:19
2:19
![Обитель зла 2: Апокалипсис | Resident Evil: Apocalypse (2004)]() 1:37:50
1:37:50
![Я иду искать 2 | Ready or Not 2: Here I Come (2026)]() 1:47:56
1:47:56
![Острые козырьки: Бессмертный человек | Peaky Blinders: The Immortal Man (2026)]() 1:54:08
1:54:08
![Zомбилэнд: Контрольный выстрел | Zombieland: Double Tap (2019)]() 1:39:05
1:39:05
![Последствия | Outcome (2026)]() 1:23:53
1:23:53
![На помощь! | Send Help (2026)]() 1:52:59
1:52:59
![Военная машина | War Machine (2026)]() 1:49:24
1:49:24
![Лакомый кусок | The Rip (2025)]() 1:52:50
1:52:50
![Вершина | Apex (2026)]() 1:35:30
1:35:30
![Проект «Конец света» | Project Hail Mary (2026)]() 2:36:35
2:36:35
![Полный такос | Operation Taco Gary's (2026)]() 1:26:14
1:26:14
![Грозовой перевал | Wuthering Heights (2026)]() 2:16:14
2:16:14
![Крик 7 | Scream 7 (2026)]() 1:53:59
1:53:59
![GOAT: Мечтай по-крупному | GOAT (2026)]() 1:39:46
1:39:46
![Сестра | Siseuteo (2026)]() 1:26:45
1:26:45
![Хамнет: История, вдохновившая «Гамлета» | Hamnet (2025)]() 2:05:47
2:05:47
![Джо едет в колледж | Joe's College Road Trip (2026)]() 1:51:29
1:51:29
![Спрингстин. Избавь меня от небытия | Springsteen: Deliver Me from Nowhere (2025)]() 1:59:36
1:59:36
![Частная жизнь | Vie privée (2025)]() 1:47:21
1:47:21
![Хищный рывок | Thrash (2026)]() 1:26:13
1:26:13
![Мультфильмы военных лет | Специальный проект к 80-летию Победы]() 7:20
7:20
![Мартышкины]() 7:10
7:10
![Сборники «Зебра в клеточку»]() 45:30
45:30
![Истории Баданаму Сезон 1]() 10:02
10:02
![Корги по имени Моко. Волшебный мир снов]() 8:60
8:60
![МегаМен: Полный заряд Сезон 1]() 10:42
10:42
![Супер Дино]() 12:41
12:41
![МиниФорс Сезон 1]() 13:12
13:12
![Новогодние мультики – Союзмультфильм]() 7:04
7:04
![Роботы-пожарные]() 12:31
12:31
![Полли Покет Сезон 1]() 21:30
21:30
![Пластилинки]() 25:31
25:31
![Папа Супергерой Сезон 1]() 4:28
4:28
![Герой внутри]() 1:09
1:09
![Корги по имени Моко. Новый питомец]() 3:28
3:28
![Пингвиненок Пороро]() 7:42
7:42
![Супер Зак]() 11:38
11:38
![Врумиз. 1 сезон]() 13:10
13:10
![Майло]() 0:25
0:25
![Корги по имени Моко. Домашние животные]() 1:13
1:13
![Антиреспект - Тишины хочу]() 4:33
4:33
![Сборник Новогодняя Десятка - Уральские Пельмени]() 1:19:08
1:19:08
![Гордость и предубеждение | Pride & Prejudice (2005)]() 2:08:21
2:08:21
![Сборник На Кухне | Уральские Пельмени]() 1:30:27
1:30:27
![Три Кота 🐱 Сборник серий подряд | Смотреть онлайн развивающие мультики и игры для детей и малышей]() 3:16:51
3:16:51
![Лучшие в Аду (2022)]() 1:49:08
1:49:08
![Винни-Пух. 1969 год.]() 41:23
41:23
![Женщина лёгкого похудения - Уральские Пельмени]() 1:12:19
1:12:19
![Аватар: Путь воды (2022)]() 3:12:39
3:12:39
![Дьявол носит Prada | The Devil Wears Prada (2006)]() 1:49:29
1:49:29
![Аватар 3: Пламя и пепел фильм, 2025]() 3:09:06
3:09:06
![Сборник Синий Трактор]() 57:36
57:36
![Снова в деле (2025) Netflix]() 1:54:23
1:54:23
![Форсаж 6 | Furious 6 (2013)]() 2:11:07
2:11:07
![Ми–Ми–Мишки 💫 Звездная история 🙃 Все серии ✨ Мультики для детей]() 2:10:31
2:10:31
![Малыш. / 2026./ Россия / Боевик Драма Война]() 1:49:28
1:49:28
![КАМИН 4К 🔥 FIREPLACE 4K | Звуки камина и Треск огня]() 2:00:00
2:00:00
![Ми–Ми–Мишки 💫 Звездная история 🙃 Все серии ✨ Мультики для детей]() 2:10:31
2:10:31
![Зверополис | Zootopia (2016)]() 1:48:48
1:48:48
![Цып-Цып - Мультики для детей - Все серии подряд!]() 1:45:28
1:45:28

 2:23:16
2:23:16Скачать Видео с Рутуба / RuTube
| 480x288 |
 3:45
3:45
2026-04-29 14:24
2026-04-30 11:44
 2:26
2:26
2026-04-23 13:18
 2:34
2:34
2026-04-23 11:07
 2:30
2:30
2026-04-28 09:53
 3:04
3:04
2026-04-23 11:16
 2:54
2:54
2026-04-29 11:48
 3:15
3:15
2026-04-21 09:41
 3:50
3:50
2026-04-21 10:26
 2:16
2:16
2026-04-20 16:39
 2:45
2:45
2026-04-23 11:37
 2:15
2:15
2026-04-17 12:38
 2:41
2:41
2026-04-29 11:40
 3:44
3:44
2026-04-28 12:53
 2:59
2:59
2026-04-27 17:01
 2:41
2:41
2026-04-10 09:47
 4:04
4:04
2026-04-10 10:01
 2:44
2:44
2026-04-10 09:57
 2:50
2:50
2026-04-09 09:20
 2:19
2:19
2026-04-23 11:42
0/0
 1:37:50
1:37:50
2026-02-25 19:41
 1:47:56
1:47:56
2026-04-12 17:20
 1:54:08
1:54:08
2026-03-21 11:57
 1:39:05
1:39:05
2026-02-16 01:07
 1:23:53
1:23:53
2026-04-17 14:43
 1:52:59
1:52:59
2026-03-27 14:10
 1:49:24
1:49:24
2026-03-10 12:44
 1:52:50
1:52:50
2026-02-04 10:11
 1:35:30
1:35:30
2026-04-30 16:00
 2:36:35
2:36:35
2026-04-11 16:06
 1:26:14
1:26:14
2026-04-07 11:13
 2:16:14
2:16:14
2026-04-20 11:54
 1:53:59
1:53:59
2026-04-22 11:21
 1:39:46
1:39:46
2026-03-27 02:41
 1:26:45
1:26:45
2026-03-27 13:34
 2:05:47
2:05:47
2026-02-06 18:40
 1:51:29
1:51:29
2026-02-26 14:41
 1:59:36
1:59:36
2026-02-13 14:02
 1:47:21
1:47:21
2026-04-09 22:40
 1:26:13
1:26:13
2026-04-29 20:33
0/0
 7:20
7:20
2025-05-03 12:34
 7:10
7:10
2025-12-30 18:33
 45:30
45:30
2025-12-11 18:53
2021-09-22 21:29
 8:60
8:60
2025-12-09 11:58
2021-09-22 21:43
 12:41
12:41
2024-11-28 12:54
2021-09-23 00:15
 7:04
7:04
2023-07-25 00:09
2021-09-23 00:12
2021-09-22 23:09
 25:31
25:31
2022-04-01 14:30
2021-09-22 21:52
 1:09
1:09
2026-04-03 12:21
 3:28
3:28
2025-01-09 17:01
 7:42
7:42
2024-12-17 12:21
2021-09-22 22:07
2021-09-24 16:00
 0:25
0:25
2026-04-10 13:19
 1:13
1:13
2024-11-29 14:40
0/0
 4:33
4:33
2019-12-02 21:15
2026-01-01 13:59
 2:08:21
2:08:21
2023-05-03 20:56
2025-04-04 18:26
 3:16:51
3:16:51
2025-10-03 19:48
2022-10-20 11:01
2023-11-19 12:01
2025-04-18 22:01
2025-06-17 19:00
 1:49:29
1:49:29
2023-04-27 15:40
2025-12-26 16:56
2024-11-13 13:06
 1:54:23
1:54:23
2025-01-18 20:05
 2:11:07
2:11:07
2023-04-25 22:52
2024-01-17 17:34
2026-04-23 21:12
2024-12-19 00:00
2024-01-17 17:34
 1:48:48
1:48:48
2024-12-16 19:01
2022-06-06 09:02
0/0

